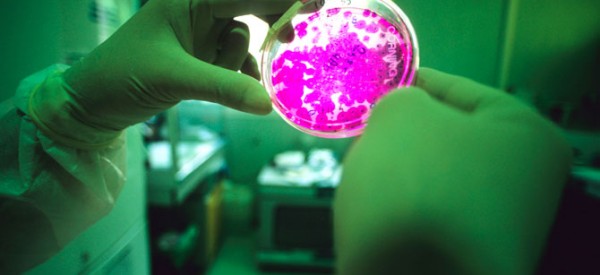

Possibility Of First Head Transplant Fraught With Ethical And Medical Dilemmas
Possibility Of First Head Transplant Fraught With Ethical And Medical Dilemmas.
Possibility Of First Head Transplant Fraught With Ethical And Medical Dilemmas.
A First: Human Liver Created from Stem Cells : Discovery News.

Atomic Van der Waals force measured for the first time – physicsworld.com.